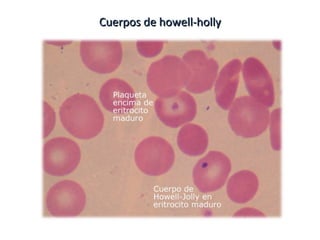
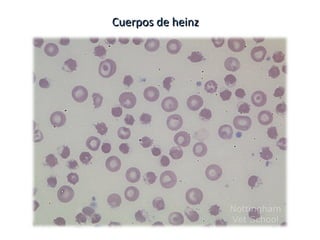
Cuerpos de heinzCuerpos de heinz
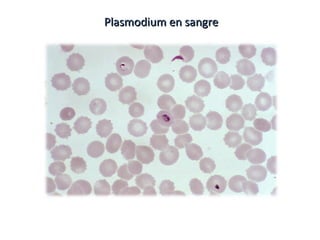
Plasmodium en sangrePlasmodium en sangre

Incrustar presentación
Descargar para leer sin conexión








Este documento lista varios tipos de inclusiones que pueden encontrarse en glóbulos rojos, incluyendo cuerpos de Howell-Jolly, cuerpos de Heinz, trypanosomas, plasmodios, y dos menciones de anillos de Cabot.